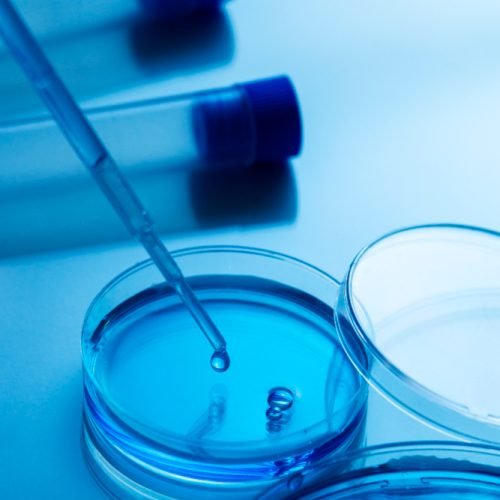
2151134921

Get To know More PEPTIBION
At PEPTIBION, we believe that optimal health begins at the molecular level. Our mission is to unlock the body’s natural potential through the science of peptides — precise amino acid chains that support repair, rejuvenation, and performance from within. Combining innovation with integrity, we provide high-quality, research-backed peptide formulations designed to enhance recovery, boost energy, improve skin health, and promote overall vitality. Every product we offer is crafted with a commitment to purity, safety, and effectiveness — empowering you to feel and perform at your best, naturally.
Learn About Our Company’s Mission & Vision
Our mission is simple — elevate research peptide testing standards across the industry ensuring all products are:
- pure (above 99%)
- sterile
- free of bacterial contamination
- no detectable heavy metals (goal late 2025)
Product sourcing
- Raw peptide ingredients produced by an FDA registered manufacturer
- Peptides finished in a GMP-compliant or GMP-certified facility
- Third party testing conducted by a federally audited, ISO certified analytical lab

